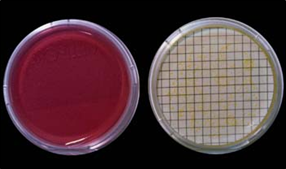
Manitol Salt Agar , rojo, con Staphylococcus aureus: colonias amarillas con gran halo amarillo del medio que inicialmente era rojo.
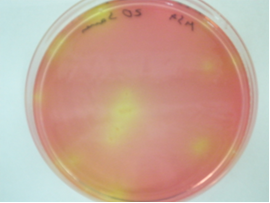
Staphylococcus aureus: colonias amarillas con gran halo de viraje a amarillo del medio rojo.

MANNITOL SALT AGAR (CHAPMAN MANNITOL) es el medio de cultivo más clásico para la detección selectiva de Staphylococcus aureus por fermentación del mannitol, empleado en microbiología clínica, en medicamentos y en cosméticos
Aislamiento de Estafilococos (USP 31armonizada), ISO 22718 (cosméticos)
COMPOSICIÓN
- Triptona 5,0 g
- Peptona de carne 5,0 g
- Extracto de carne 1,0 g
- Cloruro sódico 75,0 g
- D-Mannitol 10,0 g
- Rojo fenol 25,0 mg
- Agar agar 15,0 g
(Fórmula por litro)
pH final: 7,4 ± 0,2
PREPARACIÓN
Disolver 111 g de medio en 1 litro de agua destilada.
Calentar hasta ebullición,agitando para su disolución.
Autoclavar a 121 ºC durante 15 minutos.
PARA USO EXCLUSIVO EN LABORATORIO. AGITE EL BOTE ANTES DE USAR, PARA ASEGURAR LA HOMOGENEIZACIÓN DE LOS EVENTUALES GRADIENTES DE DENSIDAD DE LOS COMPONENTES. MANTENGA EL BOTE BIEN CERRADO EN LUGAR SECO, FRESCO Y OSCURO.
DESHIDRATADO CODIGO: DMT078
Manitol Salt Agar , rojo, con Staphylococcus aureus: colonias amarillas con gran halo
amarillo del medio que inicialmente era rojo.
CONTROL DE CALIDAD DEL MEDIO
Realizado en nuestro laboratorio; es prudente repetirlo en su laboratorio siempre que varíen las condiciones (más de 3 meses sin usar, tras desinfectar laboratorio, tras conservar a alta Tª, cuando adquiere aspectos extraños aunque no haya llegado la fecha de caducidad teórica de la etiqueta,…)
DESHIDRATADO: Polvo grueso, Rosado PREPARADO: Estéril, Rojo
CONTROL DE CRECIMIENTO CUANTITATIVO 48 h a 37°C aprox:
- Staphylococcus aureus MKTA 6538P, Correcto, Colonias blancas, Medio amarillo. Con respecto a TSA standarizado*, recuento 66-84 %, pero de forma más selectiva.
- Staphylococcus epidermidis MKTA 12228, Aceptable, Colonias rosas-blancas, Medio rosa. Respecto a TSA standard*, recuento 122 %, pero más selectivamente.
- E.coli MKTA 25922, Inhibido.
* El que cumple con recuperación superior al 92-125% con respecto a cepas cuantitativas trazables a la cepa tipo.
PRESENTACIÓN: TUBOS 20 ml, FRASCOS,
MEDIO DESHIDRATADO, PLAQUITAS HERMÉTICAS MF.
NOTA: Medio indicado para aislamiento e identificación presuntiva de Staphylococcus aureus. Se trata de un medio hipersalino (7,5%) que inhibe el crecimiento de la mayoría de microorganismos acompañantes. La producción de ácido por fermentación del manitol hace virar el rojo fenol a amarillo. Los estafilococos patógenos, coagulasa positivos, crecen óptimamente con colonias grandes, amarillas y rodeadas por un halo amarillo. Los demás estafilococos crecen con colonias pequeñas y de otros colores. Medio recomendado por la USP XXXI armonizada.
SIEMBRA
Fundir tubos 20 ml y frascos para elaborar placas. Sembrar en la superficie de placas, 0,1 ml de muestra, extendiéndola con un triángulo de vidrio estéril (VRR154) o con asas de Digralsky desechables (VCL155). Incubar a 37 ºC aproximadamente, 36 horas. Si se incuba más tiempo, en caso positivo, el viraje amarillo de S.aureus se extenderá a toda la placa y no se distinguirá visualmente de sus acompañantes.
INTERPRETACIÓN
S. aureus: Colonias grandes y amarillas, con halo amarillo. S. epidermidis: Colonias pequeñas no amarillas y sin halo. Confirmar la coagulasa con látex inmediato KWD094. Para mayor selectividad usar Agar Baird Parker, pero sólo en muestras con alta flora acompañante (ciertos alimentos, nunca en aguas o cosméticos) o mejor Cromokit-X-Staph. Para descartar los falsos positivos de Micrococos, realizar una citocromo-oxidasa (con las tiras estables KOT050), ya que los Staphylococcus spp. son oxidasa negativos pero los Micrococcus spp. son oxidasa positivos.
El usuario final es el único responsable de eliminar los microorganismos de acuerdo con la legislación medioambiental vigente. Autoclavar antes de desechar a la basura.
Si desea más información sobre nuestros MANNITOL SALT AGAR (CHAPMAN MANNITOL), rellene nuestro formulario de contacto http://www.medioscultivo.com/contacto . O si lo prefiere póngase en contacto con nosotros a través de nuestro correo electrónico microkit@microkit.es o por teléfono en el nº 91-897 46 16